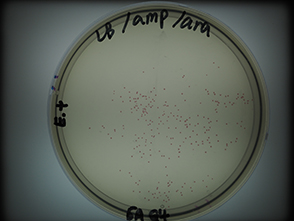

Amgen Biotech Experience (ABE) Programme
The Chinese University of Hong Kong and The Amgen Foundation collaborate to introduce “Amgen Biotechnology Experience (ABE) Programme” to Hong Kong schools, so that teachers can bring biotechnology experiments to real practice in the lessons. This enables students to unveil the details of daily applications of biotechnology nowadays. It has been the third year of our school to join the ABE Programme. Biotechnology experiments were conducted in late May. All S.5 Biology students learnt how to successfully transform Red Fluorescent Protein (RFP) gene into Escherichia coli bacterial cells, amplify target gene by 1 million times within an hour through Polymerase Chain Reaction (PCR) and separate various plasmids of different molecular sizes by agarose gel electrophoresis. Our school has extended this precious learning experience to S.3 students as a Popular Science Workshop as well, in which interested students can get hands-on experience for biotechnology experiments so that they can plan for their Science projects at their earliest.